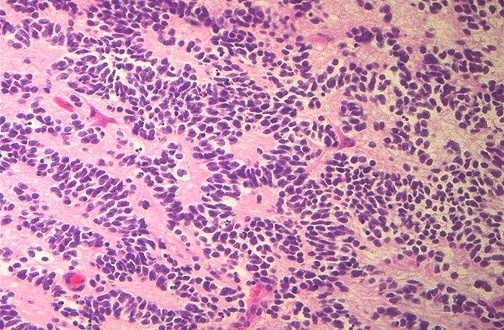
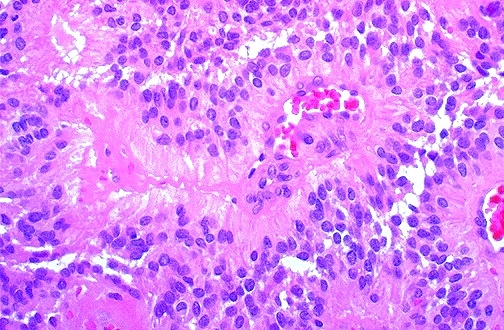
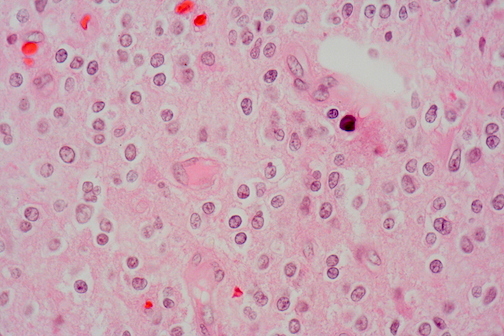

Vasogenic edema - pale areas

Subacute infarct - foamy macrophages

The subarachnoid hemorrhage from a ruptured aneurysm shown here at the base of the brain is more of an irritant producing vasospasm than a mass lesion. However, a large aneurysm could act like a mass and press on the brainstem or cranial nerve.

PD midbrain loss of substantia nigra

Meningioma
benign
attached to dura
encapsulated
en plaque growt - sheet like spread
syncytial / fibroblastic / transitional/ psammomatous (whorls of cells)
Medulloblastoma - Homer Wright

Lewy bodies
At the left, an H&E stain shows a rounded pink cytoplasmic Lewy body in a neuron of the cerebral cortex from a patient with diffuse Lewy body disease, which can be a cause for dementia. Lewy bodies can also be seen in substantia nigra with Parkinson disease. An immunohistochemical stain for ubiquitin, seen at the right, helps demonstrate the Lewy bodies more readily by the collection of intense brown reaction product within them.

Lacunar infarct - cystic space due to liquefactive necrosis

Glioblastoma - pseudo pallisading cells, cystic degeneration, anaplastic, necrosis

Glioblastoma gross - hemorrhage, firm white / soft yellow
Primary: xPTEN, EGFR^, xCDKN2A
Secondary: xTP53, IDH1/2 (longer survival), PDGFR^

Glioblastoma
Ependymoma, vascular rosettes

Cystic space, liquefactive necrosis

Cerebral edema shift of midline to the left

Cerebral edema wide gyri narrow sulci

Bacterial meningitis - neutrophilic exudate

Astrocytoma
Diffuse - poorly defined, gray, greater cellularity, GFAP+
Localized (pylocytic - cystic, in children, bipolar cells with long thin hairlike processes Rosenthal fibers
Anaplastic - dense cellularity, nuclear pleomophism, mitotic figures
Gemistocytic - astrocytes with brightly eosinophilic bodies, stout processes (swollen, reactive astrocyte)

AD neurofibrillary tangle

AD neuritic plaques - Congo Red

Acute cerebral infarct

Abscess - trichrome blue shows CT

Substantia nigra left normal right PD
Oligodendroglioma
fried egg, calcifications, anastomosing capillaries, no mitotic activity, well circumscribed

Oligodendroglioma
Solid sheets with finely granular nuclear chromatin, surrounded by a halo of vacuolated cytoplasm


